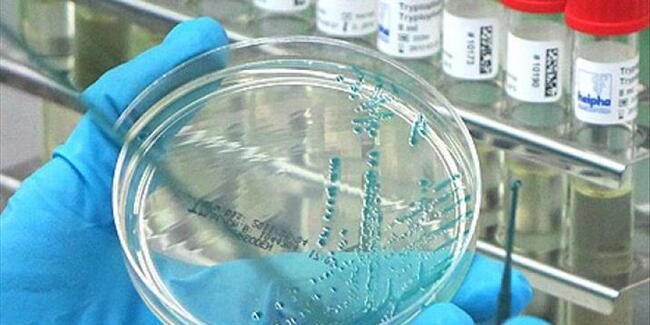

Tarım Bakanlığınca resmi gazetede yayımlanan kararnameyle göçmen kuşların, rotaları üzerindeki yerlere kuş gribi taşıması riski bulunduğu için 45 bölgedeki kümes hayvanlarının karantinaya alınması ya da güvenlik ağıyla korunması zorunlu kılındı.
Pazarlarda canlı kümes hayvanı satışı ile avcıların av kuşlarını kullanması da yasaklandı.
Kaz ciğeri üretimiyle bilinen Landes ve Gers bölgeleri, “riskli bölgeler” arasında bulunuyor.
Ülkenin güneybatısındaki bölgelerde, 2015-2016 ve 2016-2017 kış mevsimlerinde görülen iki kuş gribi salgınında milyonlarca hayvan itlaf edilmişti.
Salgınlar, Fransa’nın ihracat gelirlerinde milyonlarca dolar zarara yol açmıştı.
HOLLANDA’DA 200 BİN TAVUK İTLAF EDİLECEK
Hollanda Tarım Bakanlığı, doğudaki Puiflijk kasabasındaki bir çiftlikte son derece patojenik kuş gribi tespit edilmesi üzerine 200,000 tavuğun itlaf edilmesi talimatı verdi.
1 km yarıçapındaki ikinci bir çiftlikte bulunan kuşları kapsayacak itlaf, H5N8 hastalığının ilk olarak yabani kanatlılarda görülmesinden sonra bu ay ülkede ikinci oldu.
Hollandalı kümes hayvanı çiftçilerine bulaşmayı önlemek için kuşları içeride tutmaları talimatı verildi.
CNN